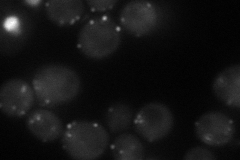
YGL211W

View description
Protein required for thiolation of the uridine at the wobble position of Gln, Lys, and Glu tRNAs; has a role in urmylation and in invasive and pseudohyphal growth; inhibits replication of Brome mosaic virus in S. cerevisiae
Localization:
Intensity:
Fold change:
Significance:
-
C’ GFP library in SD

below threshold14.1 -
N' NOP1pr-GFP in SD
punctate48.5155 -
N' TEF2pr-mCherry in SD

punctate14.4132 -
N' NATIVEpr-GFP in SD

below threshold19.1713 -
N' TEF2pr-VC and Cyto-VN in SD

#N/A0 -
C’ GFP library in SD+DTT

cytosol13.630.96No -
C’ GFP library in SD+H2O2

cytosol15.921.12No -
C’ GFP library in Starvation Media

cytosol23.181.64No -
C’ GFP library on the background of Pup2-DaMP

N/A -
C’ GFP library on the background of CCT mutant

N/A0N/AYes
